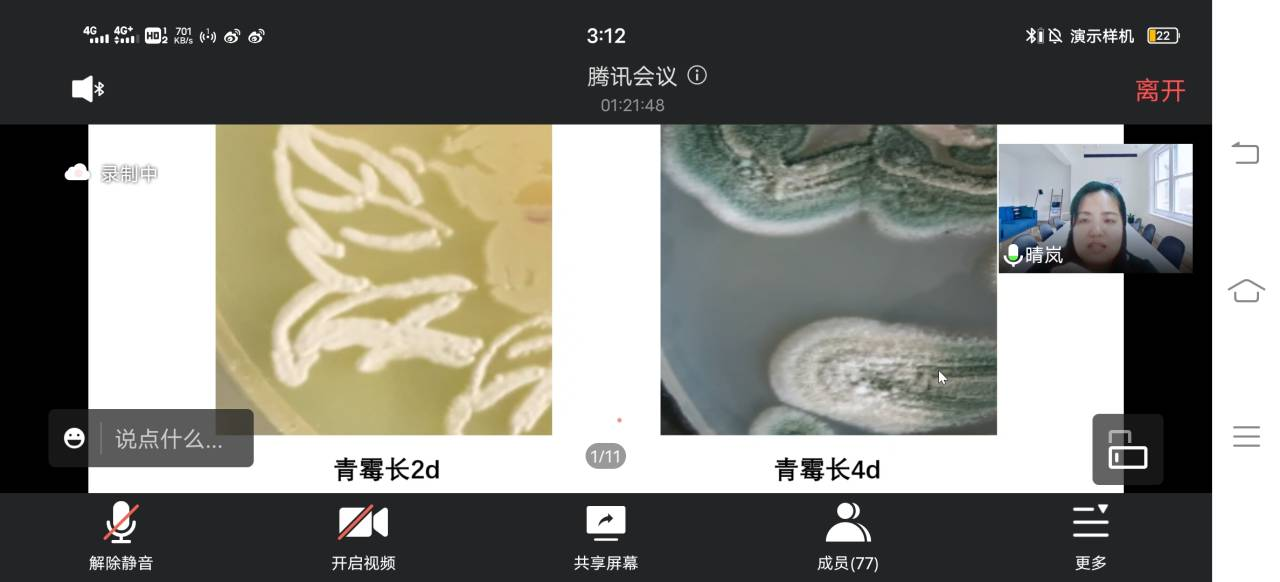

6月1日,应中国科学院微生物研究所邀请,beat365官网生命科学学院郑爱芳副教授为该所研究生会Micro-STAR科研技能学术沙龙作线上学术交流,主题为微生物绘画(培养皿艺术)技术经验交流,70多名师生参加了线上交流会。
郑爱芳首先介绍了微生物绘画的起源发展、绘制流程、注意事项等内容,结合自己指导的第七届全国青年科普创新实验暨作品大赛一等奖作品《国色露华浓》,将微生物绘画(培养皿艺术)的操作过程、蕴含的科学知识进行了生动、详细的讲解。在讲授过程中,她展示了自己所带学生团队近年来的获奖作品,让与会人员进行现场讨论,然后进行总结点评,结合不同获奖案例深入分析了微生物绘画作品的操作流程和技术难点。
交流会上,郑爱芳还进行了线上互动答疑,针对不同微生物绘画作品采用的各类菌种、绘制与处理方法、注意事项同与会师生进行了交流分享。“为什么同一种菌最后颜色不同?”“如何控制霉菌的生长?”“微生物平皿画可以保存几天?”……现场提问环节气氛热烈,郑爱芳耐心地进行了专业的解答,受到与会师生的一致好评。
培养皿艺术近年来在微生物学领域受到热烈追捧,国内外相关单位和机构举行了多项赛事,在社会上引起广泛关注。通过展示微生物绘画作品(培养皿艺术)不仅可以让普通大众欣赏微生物之美,科普微生物知识,同时也能让科研人员在科学中发现美,将美育融于科学,享受科学之美。
与会师生表示获益匪浅,特别是学到了以前未曾掌握的微生物绘画(培养皿艺术)相关技术经验,提升了大家对微生物知识的学习兴趣,并将运用所学知识和技巧用于微生物绘画实践中。(撰稿、摄影:郑爱芳 编辑:管婷婷 审核:张辉 汪德进)